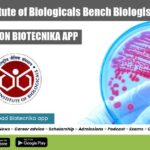
NIB Bench Biologist Job

Home Search
microbiology - search results
If you're not happy with the results, please do another search
Bureau of Indian Standards (BIS) Recruitment 2022, Online Applications Invited
BIS Jobs 2022 - Bureau of Indian Standards (BIS) Recruitment 2022
BIS Jobs 2022 - Bureau of Indian Standards (BIS) Recruitment 2022. BIS Microbiology Jobs...
Biotecnika Times Newsletter 18.04.2022 Britannia Recruitment, Govt BCIL High Pay, CSIR-IGIB
Biotecnika Times - Britannia Recruitment, Govt BCIL High Pay, CSIR-IGIB
CSIR-IGIB PhD 2022 Program Notification – Applications Invited
CSIR-IGIB PhD 2022 Program Notification – Applications Invited....
Biotecnika Times Newsletter 15.04.2022 JNCASR Summer Program With Stipend, BIRAC
Biotecnika Times - JNCASR Summer Program With Stipend, BIRAC
JNCASR Summer Research Fellowship Program 2022 (SRFP) With Rs. 10,000 pm Stipend For Life Sciences
JNCASR Summer...
Associate Manager – Quality Assurance Opportunity at Pfizer
Pfizer QA Job For Microbiology - Associate Manager Vacancy
Pfizer QA Job For Microbiology - Associate Manager Vacancy. Pfizer is hiring candidates for an Associate...
Biotecnika Times Newsletter 14.04.2022 CIAB Fellowships, IISc Admission 2022, Govt GBRC
Biotecnika Times - CIAB Fellowships, IISc Admission 2022, Govt GBRC
IISc UG Admission 2022-23 – Four-Year BSc (Research) Programme
IISc UG Admission 2022-23 – Four-Year BSc...
Gujarat Biotechnology Research Centre Recruitment 2022, Apply Online
GBRC Jobs 2022 - MSc/ MTech & PhD Research Job Openings
GBRC Jobs 2022 - MSc/ MTech & PhD Research Job Openings. GBRC Jobs 2022...
CIAB Fellowships 2022 – JRF & Research Associate Recruitment
CIAB Fellowships 2022 - JRF & Research Associate Recruitment
CIAB Fellowships 2022 - JRF & Research Associate Recruitment. MSc/ MTech/ BTech, PhD & ME Life...
Biotecnika Times Newsletter 13.04.2022 10+ CSIR-CCMB Project Openings, Govt GPCB
Biotecnika Times - 10+ CSIR-CCMB Project Openings, Govt GPCB
10+ CSIR-CCMB Project Openings For Life Sciences With Up To Rs. 56,000 pm Pay
CSIR-CCMB Project Openings....
10+ CSIR-CCMB Project Openings For Life Sciences With Up To Rs. 56,000 pm Pay
CSIR-CCMB Project Openings For Life Sciences With Up To Rs. 56,000 pm Pay
CSIR-CCMB Project Openings. 10+ CSIR-CCMB Project Openings For Life Sciences With Up...
IBSD Project Associate Job Openings For Biotech, Biochem, Life Sciences
IBSD Project Associate Job Openings For Biotech, Biochem, Life Sciences
IBSD Project Associate Job Openings For Biotech, Biochem, Life Sciences. Microbiology, Molecular Biology job openings....
Pall Corporation Biotech Specialist Recruitment, Apply Online
Pall Corporation Biotech Specialist Recruitment, Apply Online
Pall Corporation Biotech Specialist Recruitment, Apply Online. Danaher Life Sciences companies jobs. Hyderabad biotech specialist vacancies. Check out...
Biotecnika Times Newsletter 12.04.2022 25+ CSIR-CDRI Jobs, NIB Bench Biologist Job, CDFD
Biotecnika Times- 25+ CSIR-CDRI Jobs, NIB Bench Biologist Job, CDFD
25+ CSIR-CDRI Project Openings With Up to 56,000 pm Pay, Apply Online
CSIR-CDRI Project Openings With...
National Institute of Biologicals Bench Biologist Recruitment
NIB Bench Biologist Job Opening - Applications Invited
NIB Bench Biologist Job Opening - Applications Invited. M.Sc . in Microbiology/ Bio-Chemistry / Biotechnology / Molecular...
25+ CSIR-CDRI Project Openings With Up to 56,000 pm Pay, Apply Online
CSIR-CDRI Project Openings With Up to 56,000 pm Pay, Apply Online
CSIR-CDRI Project Openings With Up to 56,000 pm Pay, Apply Online. CSIR-CDRI Project Jobs...
NIAB Project Job For Biotech, Mol Bio, Microbio & Life Sciences, Apply Online
NIAB Vacancy 2022 - Project Associate Job Opening
NIAB Vacancy 2022 - Project Associate Job Opening. National Institute of Animal Biotechnology vacancy. MSc Life Sciences...